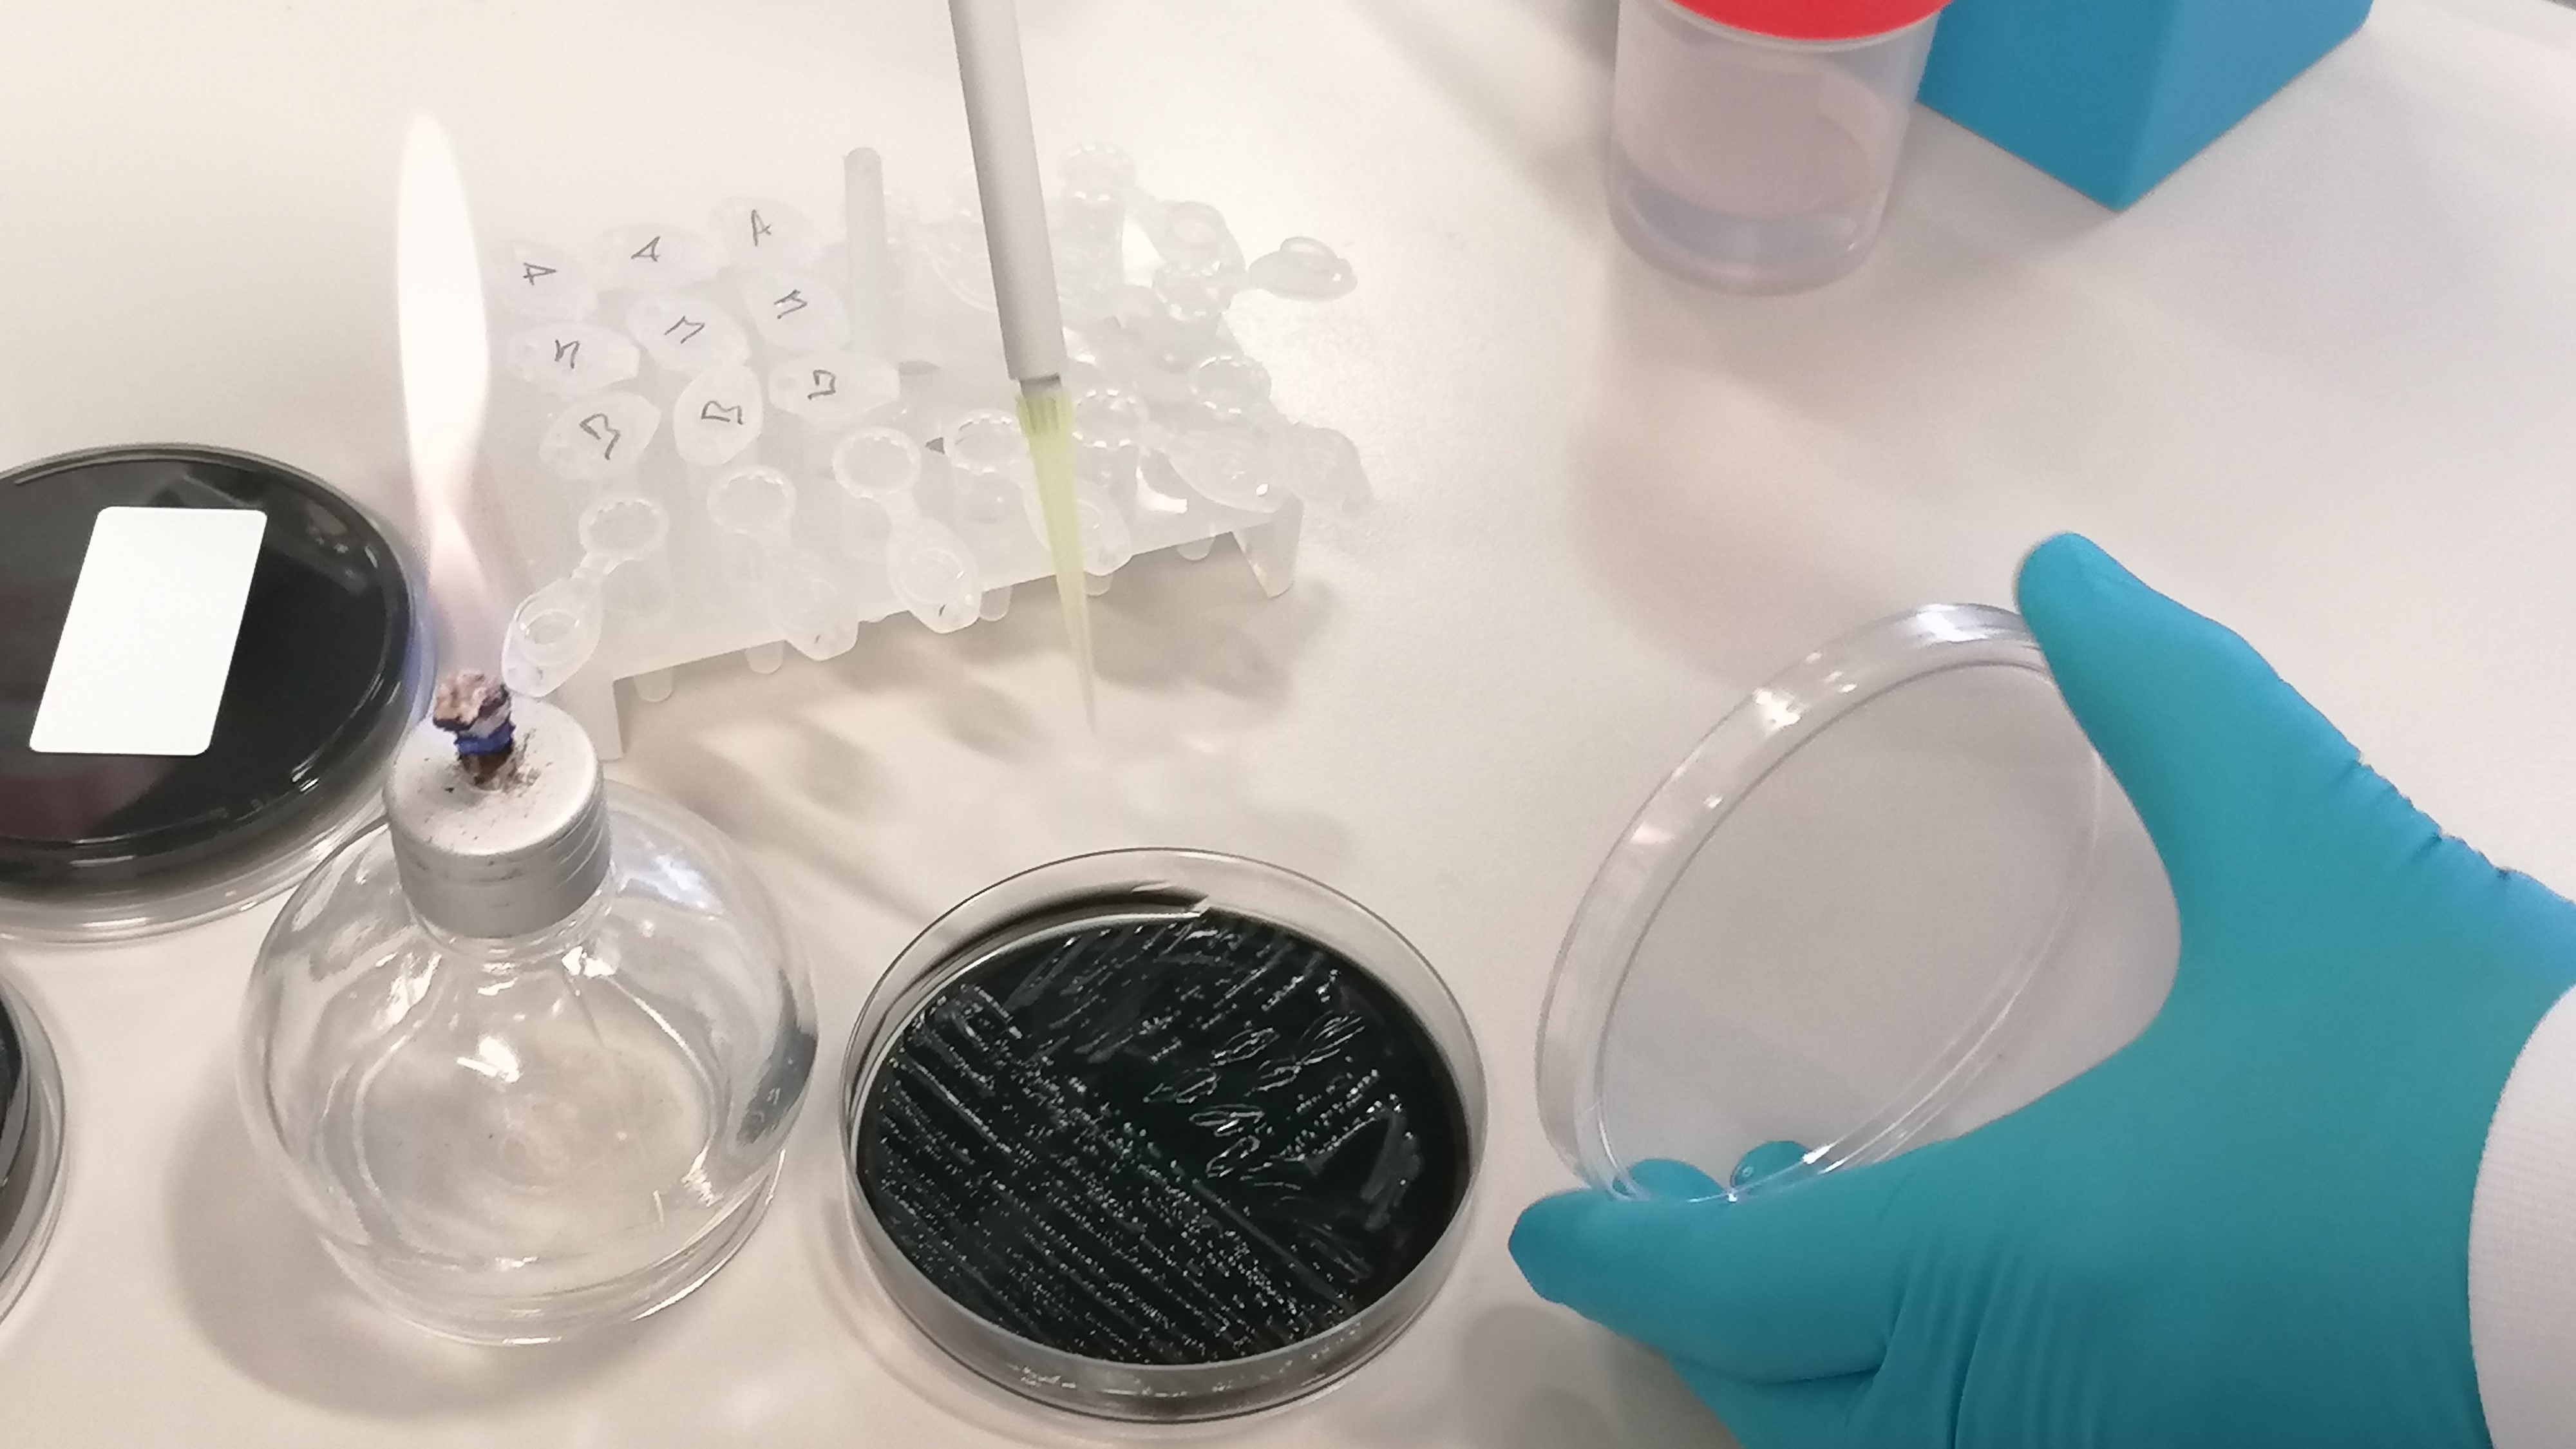

CASTELLÓ. La castellonense Biótica y un equipo de la Unidad de Legionella del Laboratorio de referencia en infecciones bacterianas transmitidas por agua y alimentos, del Centro Nacional de Microbiología (Instituto de Salud Carlos III), ha desarrollado un nuevo método para ayudar a la detección de Legionella pneumophila por medio del cultivo en placa.
Este patógeno causa la legionelosis, una neumonía pulmonar grave con síntomas como fiebre, dificultad respiratoria, dolor de cabeza, letargo, dolores musculares, diarrea y tos sanguinolenta. La incidencia en nuestro país es de las más altas de Europa. Es una enfermedad actualmente en progreso.
El método está basado en el uso de micro esferas activadas para capturar y separar el patógeno en una muestra de agua; se trata de una tecnología de bajo coste y alta sensibilidad, cuya aplicación contribuye a aislar esta bacteria en muestras complicadas, dónde la presencia de otros microorganismos impide que se pueda detectar de forma normal.
Permite además obtener información que puede utilizarse en un brote para confirmar su origen, hecho que hoy no consigue producirse hasta en un 57% de los brotes de legionelosis que ocurren en Europa. Actualmente, los resultados del cultivo son “no concluyentes” en un 20-30% de las muestras, dato que el método ahora desarrollado podría reducir o eliminar. Sus resultados están en proceso de publicarse en revistas científicas especializadas.
Según un informe hecho público recientemente por el Instituto de Salud Carlos III, sólo en 2018 se declararon 1.631 casos de legionelosis frente a los 1.493 de 2017 o los 1.020 de 2016. Estos datos muestran un aumento de los casos declarados de legionelosis en 2018, de un 57% sobre los casos de 2016, situando así a España muy por encima de la media europea. Según los expertos, cuantificar el riesgo a través del cultivo es muy problemático, porque la precisión en la cuantificación de la legionela es muy baja, el resultado depende del operador y además tarda entre 10-14 días. En este caso, Biótica ya ha desarrollado una prueba rápida que evita estos inconvenientes, Legipid®, para su aplicación en el autocontrol de instalaciones con valor preventivo. Biótica Bioquímica Analítica, S.L. es una Empresa Innovadora de Base Tecnológica (EIBT), ubicada en el Parque Científico Tecnológico y Empresarial de la Universidad Jaume I de Castelló.